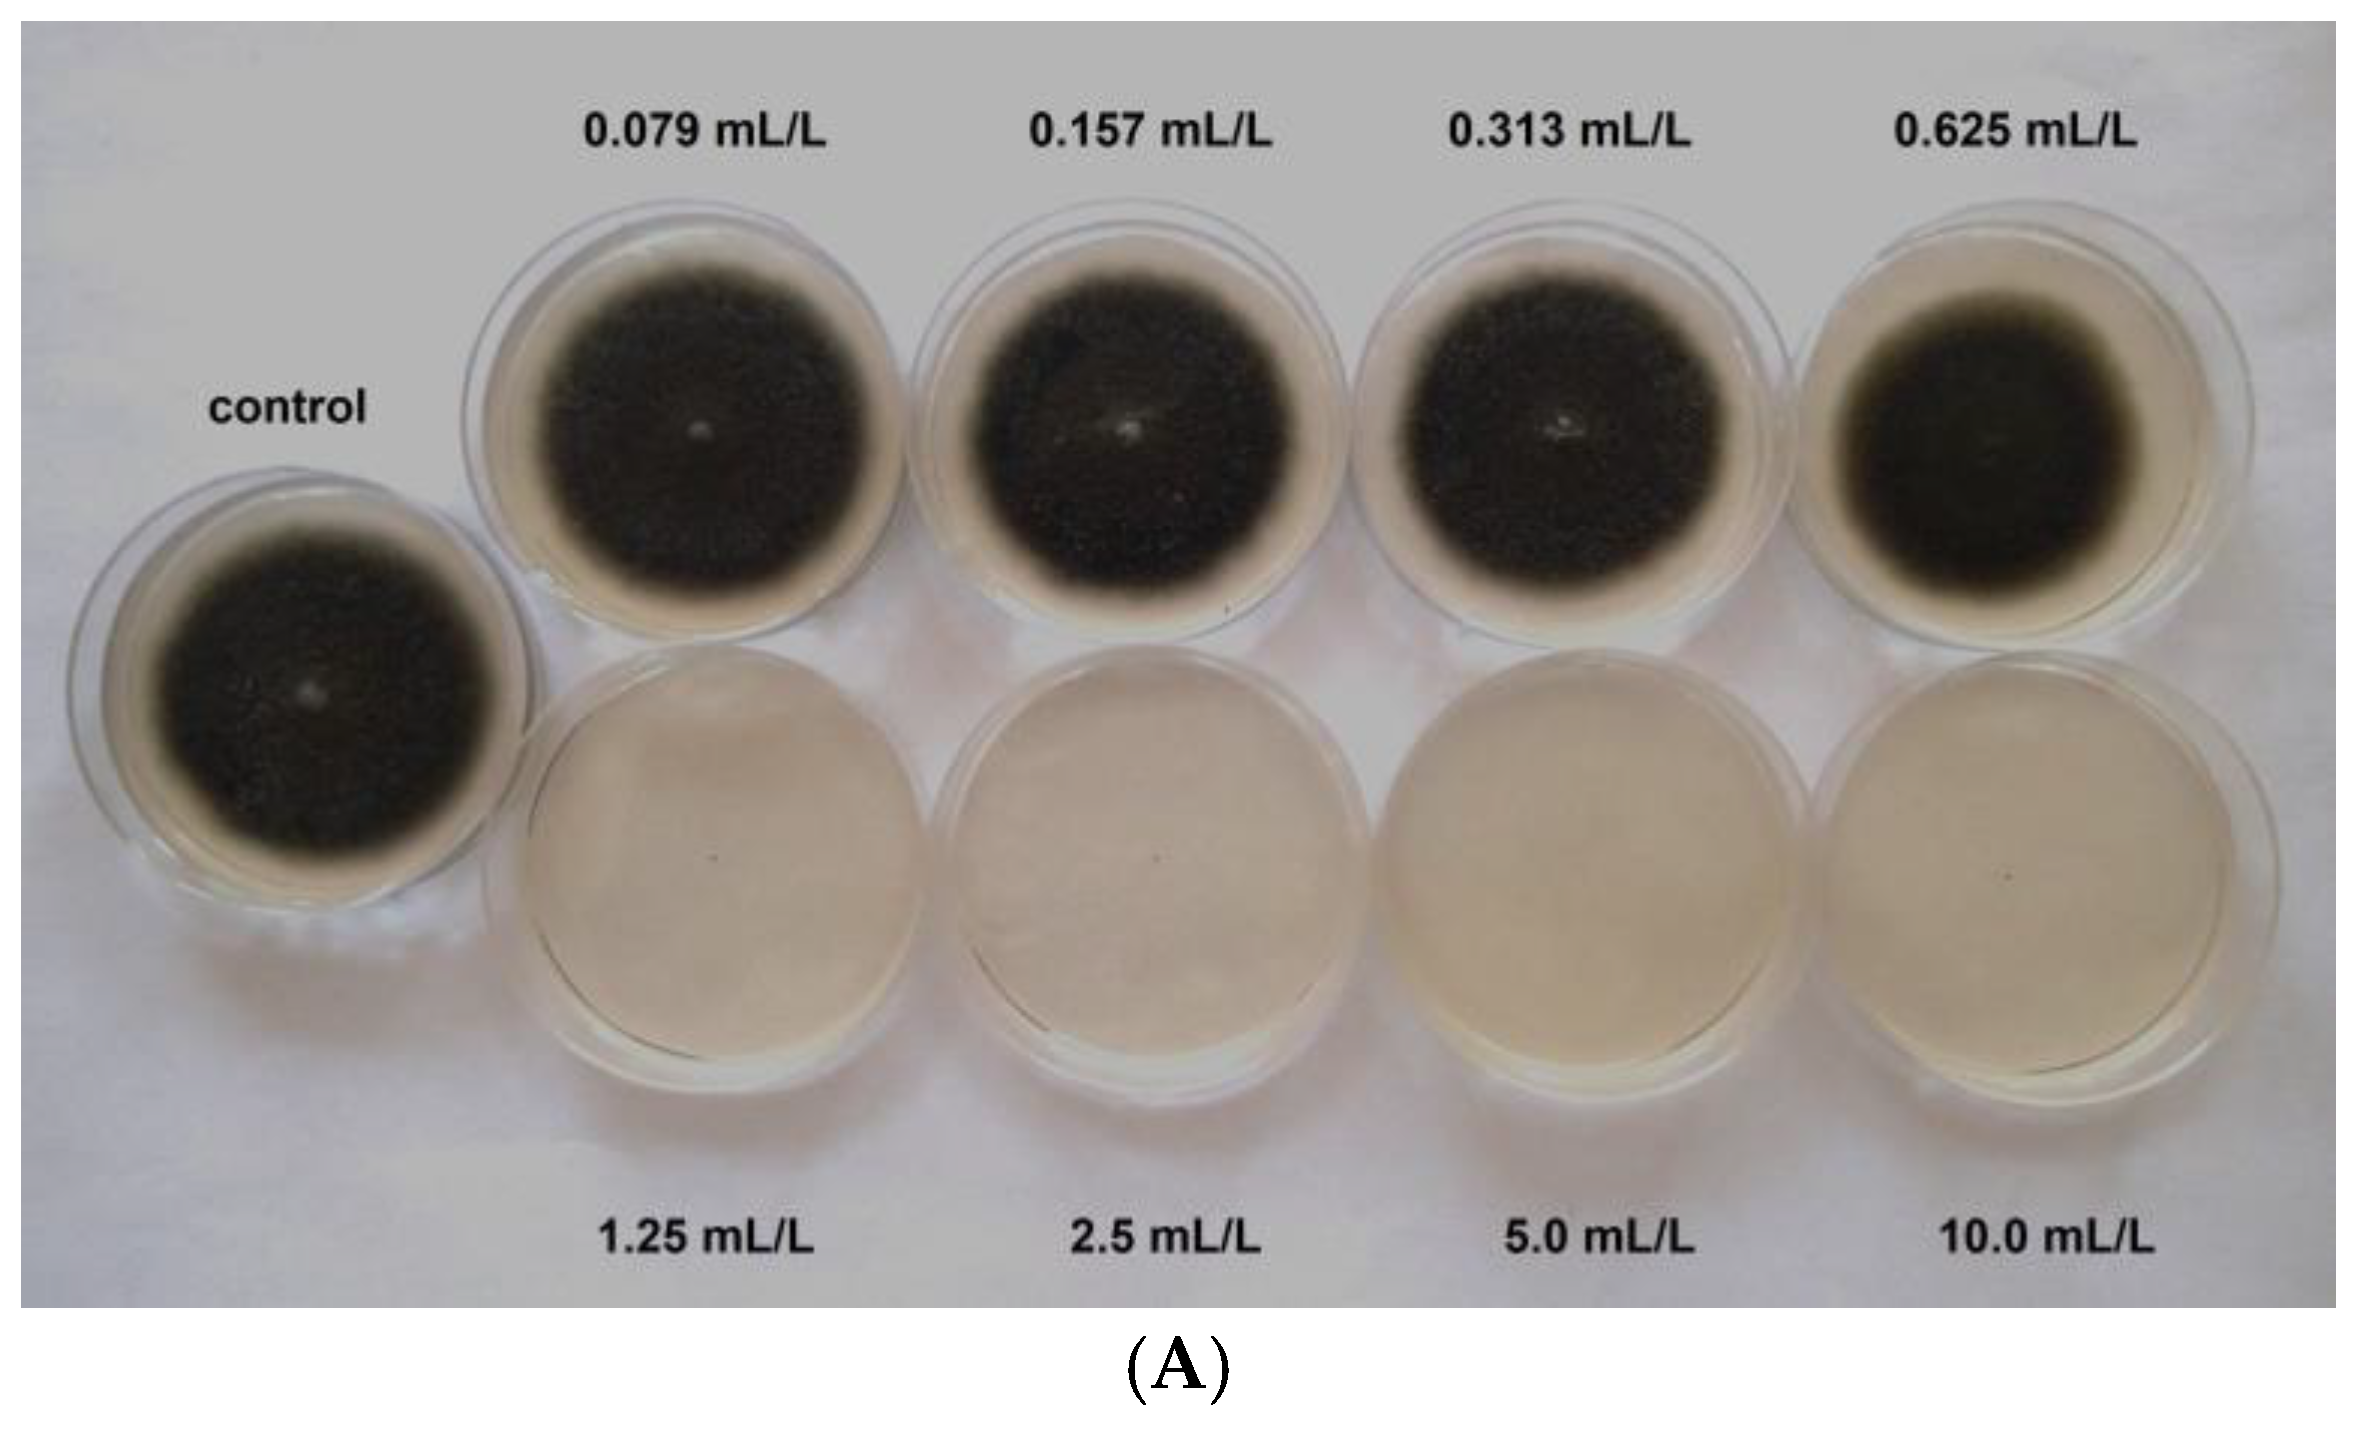
Agriculture 14 02017 g003a

The Use of Thyme (Thymus vulgaris) Essential Oil for Controlling Cercospora Leaf Spot (Cercospora beticola) on Sugar Beets (Beta vulgaris)
Abstract
1. Introduction
2. Materials and Methods
2.1. Collection of C. beticola Isolates
2.2. Resistance of Fungal Isolates Against Synthetic Fungicides
2.3. Tested Essential Oils and Analysis of Their Composition
2.4. Antifungal Activity Assays of Essential Oils
2.5. Field Experiments
2.5.1. Locations of the Experimental Fields and Their Characterization
2.5.2. Experimental Design
2.5.3. Assessment of C. beticola Infections
2.5.4. Assessment of Qualitative Parameters of the Yield
2.5.5. Statistical Analysis
3. Results
3.1. Resistance of Fungal Isolates Against Synthetic Fungicides
3.2. Essential Oils Composition Analysis
3.3. Antifungal Activity Assay of Essential Oils
3.4. Field Experiments
3.4.1. Experiments in 2022
3.4.2. Experiments in 2023
4. Discussion
5. Conclusions
Supplementary Materials
Author Contributions
Funding
Institutional Review Board Statement
Data Availability Statement
Acknowledgments
Conflicts of Interest
Sample Availability
References
- Piszczek, J.; Strażyński, P.; Mrówczyński, M. (Eds.) Metodyka Integrowanej Ochrony Buraka Cukrowego i Pastewnego Dla Doradców; Wydawnictwo Instytutu Ochrony Roślin—Państwowego Instytutu Badawczego: Poznań, Poland, 2018; p. 123ss. [Google Scholar]
- Deising, H.B.; Reimann, S.; Pascholati, S.F. Mechanisms and significance of fungicide resistance. Braz. J. Microbiol. 2008, 39, 286–295. [Google Scholar] [CrossRef] [PubMed]
- Kiniec, A.; Pieczul, K.; Piszczek, J. Evaluation of validity of the use of thiophanate-methyl in controlling Cercospora leaf spot (Cercospora beticola Sacc.) based on RFLP analysis. Prog. Plant Prot. 2019, 59, 252–257. [Google Scholar] [CrossRef]
- Rangel, L.I.; Spanner, R.E.; Ebert, M.K.; Pethybridge, S.J.; Stukenbrock, E.H.; de Jonge, R.; Secor, G.A.; Bolton, M.D. Cercospora beticola: The intoxicating lifestyle of the leaf spot pathogen of sugar beet. Mol. Plant Pathol. 2020, 21, 1020–1041. [Google Scholar] [CrossRef] [PubMed]
- Cosić, J.; Vrandečić, K.; Postić, J.; Jurković, D.; Ravlić, M. In vitro antifungal activity of essential oils on growth of phytopathogenic fungi. Poljoprivreda 2010, 16, 25–28. [Google Scholar]
- Fatouh, Y.O.; Abd-El-Kareem, F.; Abd-El-Latif, F.M.; El-Mohammedy, R.S. Effects of citrus essential oil compounds on management leaf spot disease of sugar beet plant under field condition. J. Agric. Sci. Technol. 2011, 7, 869–877. [Google Scholar]
- De Clerck, C.; Dal Maso, S.; Parisi, O.; Dresen, F.; Zhiri, A.; Jijakli, M.H. Screening of Antifungal and Antibacterial Activity of 90 Commercial Essential Oils against 10 Pathogens of Agronomical Importance. Foods 2020, 9, 1418. [Google Scholar] [CrossRef]
- Dongmo, A.N.; Nguefack, J.; Dongmo, J.B.L.; Fouelefack, F.R.; Azah, U.R.; Nkengfack, E.A.; Stefani, E. Chemical characterization of an aqueous extract and the essential oil of Tithonia diversifolia and their biocontrol activity against seed borne pathogens of rice. J. Plant Dis. Prot. 2021, 128, 703–713. [Google Scholar] [CrossRef]
- Starović, M.; Ristić, D.; Pavlović, S.; Mözkan, M.; Jošić, D. Antifungal activity of plant essential oils and Pseudomonas chlororaphis strains against Cercospora beticola Sacc. Zb. Matice Srp. Prir. Nauk. 2021, 140, 9–19. [Google Scholar] [CrossRef]
- Bakkali, F.; Averbeck, S.; Averbeck, D.; Idaomar, M. Biological effects of essential oils—A review. Food Chem. Toxicol. 2008, 46, 446–475. [Google Scholar] [CrossRef]
- Burt, S. Essential oils: Their antibacterial properties and potential applications in food—A review. Int. J. Food Microbiol. 2004, 94, 223–253. [Google Scholar] [CrossRef]
- Bozin, B.; Mimica-Dukic, N.; Simin, N. Characterization of the Volatile Composition of Essential Oils of Some Lamiaceae Spices and the Antimicrobial and Antioxidant Activities of the Entire Oils. J. Agric. Food Chem. 2006, 54, 1822–1828. [Google Scholar] [CrossRef] [PubMed]
- Soković, M.D.; Vukojević, J.; Marin, P.D.; Brkić, D.D.; Vajs, V.; van Griensven, L.J.L.D. Chemical Composition of Essential Oils of Thymus and Mentha Species and Their Antifungal Activities. Molecules 2009, 14, 238–249. [Google Scholar] [CrossRef] [PubMed]
- Ebani, V.V.; Nardoni, S.; Bertelloni, F.; Najar, B.; Pistelli, L.; Mancianti, F. Antibacterial and Antifungal Activity of Essential Oils against Pathogens Responsible for Otitis Externa in Dogs and Cats. Medicines 2017, 4, 21. [Google Scholar] [CrossRef] [PubMed]
- Masotti, V.; Juteau, F.; Bessière, J.M.; Viano, J. Seasonal and Phenological Variations of the Essential Oil from the Narrow Endemic Species Artemisia molinieri and Its Biological Activities. J. Agric. Food Chem. 2003, 51, 7115–7121. [Google Scholar] [CrossRef]
- Arbona, V.; Manzi, M.; de Ollas, C.; Gómez-Cadenas, A. Metabolomics as a Tool to Investigate Abiotic Stress Tolerance in Plants. Int. J. Mol. Sci. 2013, 14, 4885–4911. [Google Scholar] [CrossRef]
- Yan, J.; Niu, Y.; Wu, C.; Shi, Z.; Zhao, P.; Naik, N.; Mai, X.; Yuan, B. Antifungal effect of seven essential oils on bamboo. Adv. Compos. Hybrid. Mater. 2021, 4, 552–561. [Google Scholar] [CrossRef]
- Abramson, C.I.; Wanderley, P.A.; Wanderley, M.J.A.; Miná, A.J.S.; Baracho de Souza, O. Effect of Essential Oil from Citronella and Alfazema on Fennel Aphids Hyadaphis foeniculi Passerini (Hemiptera: Aphididae) and its Predator Cycloneda sanguinea L. (Coleoptera: Coccinelidae). Am. J. Environ. Sci. 2006, 3, 9–10. [Google Scholar] [CrossRef]
- Górski, R.; Piątek, H. Efficacy of natural essential oils in the control of two-spotted spider mite [Tetranychus urticae Koch] occurring on dwarf bean. Prog. Plant Prot. 2008, 48, 1347–1350. [Google Scholar]
- Sharma, N.; Tripathi, A. Fungitoxicity of the essential oil of Citrus sinensis on post-harvest pathogens. World J. Microbiol. Biotechnol. 2006, 22, 587–593. [Google Scholar] [CrossRef]
- Er, Y.; Özer, N.; Katırcıoğlu, Y.Z. Determination of anti-mildew activity of essential oils against downy mildew of sun-fower caused by Plasmopara halstedii. J. Plant Dis. Prot. 2020, 127, 709–713. [Google Scholar] [CrossRef]
- Eurostat Agricultural Production-Crops-Statistics Explained. Available online: https://ec.europa.eu/eurostat/statistics-explained/index.php?title=Agricultural_production_-_crops (accessed on 9 July 2023).
- Khan, J.; Qi, A.; Khan, M.F.R. Fluctuations in number of Cercospora beticola conidia in relationship to environment and disease severity in sugar beet. Phytopathology 2009, 99, 796–801. [Google Scholar] [CrossRef] [PubMed]
- Tedford, S.L.; Burlakoti, R.R.; Schaafsma, A.W.; Trueman, C.L. Optimizing Management of Cercospora Leaf Spot (Cercospora beticola) of Sugarbeet in the Wake of Fungicide Resistance. Can. J. Plant Pathol. 2019, 41, 35–46. [Google Scholar] [CrossRef]
- Goudet, C.; Milat, M.-L.; Sentenac, H.; Thibaud, J.-B. Beticolins, Nonpeptidic, Polycyclic Molecules Produced by the Phytopathogenic Fungus Cercospora beticola, as a New Family of Ion Channel-Forming Toxins. Mol. Plant-Microbe Interact. 2000, 13, 203–209. [Google Scholar] [CrossRef] [PubMed]
- Weiland, J.; Koch, G. Sugarbeet Leaf Spot Disease (Cercospora beticola Sacc.). Mol. Plant Pathol. 2004, 5, 157–166. [Google Scholar] [CrossRef]
- Vurro, M.; Boari, A.; Casella, F.; Zonno, M.C. Fungal Phytotoxins in Sustainable Weed Management. Curr. Med. Chem. 2018, 25, 268–286. [Google Scholar] [CrossRef]
- Shane, W.W.; Teng, P.S. Impact of Cercospora leaf spot on root weight, sugar yield, and purity of Beta vulgaris. Plant Dis. 1992, 76, 812–820. [Google Scholar] [CrossRef]
- Kiniec, A.; Piszczek, J.; Miziniak, W.; Sitarski, A. Impact of the variety and severity of Cercospora beticola infection on the qualitative and quantitative parameters of sugar beet yields. Pol. J. Agron. 2020, 41, 29–37. [Google Scholar] [CrossRef]
- Kirk, P.M.; Sivanesan, A.; Holliday, P.C.M.I. Descriptions of Pathogenic Fungi and Bacteria (Set 73), Nos. 721 Cercospora beticola; Commonwealth Mycological Institute: Kew, UK, 1982. [Google Scholar]
- Rossi, V.; Battilani, P. Cercopri: A forecasting model for primary infections of Cercospora leaf spot of sugarbeet. EPPO Bull. 1991, 21, 527–531. [Google Scholar] [CrossRef]
- Artyszak, A.; Gozdowski, D.; Siuda, A. Effect of the Application Date of Fertilizer Containing Silicon and Potassium on the Yield and Technological Quality of Sugar Beet Roots. Plants 2021, 10, 370. [Google Scholar] [CrossRef]
- Buchholz, K.; Märländer, B.; Puke, H.; Glattkowski, H.; Thielecke, K. Neubewertung des technischen Wertes von Zuckerrüben. Re-evaluation of technical value of sugar beet. Sugar Ind. 1995, 120, 113–121. [Google Scholar]
- Trzebiński, J. Ocena wydajności cukru z korzeni. In Produkcja Buraka Cukrowego; Gutmański, I., Ed.; PWRiL: Poznań, Poland, 1991; pp. 591–597. [Google Scholar]
- Kabara, J.J. Phenols and Chelators. In Food Preservatives; Russell, N.J., Gould, G.W., Eds.; Blackie: London, UK, 1991; pp. 200–214. [Google Scholar]
- Viuda-Martos, M.; Ruiz-Navajas, Y.; Fernández-López, J.; Pérez-Álvarez, J. Antifungal Activity of Lemon (Citrus lemon L.), Mandarin (Citrus reticulata L.), Grapefruit (Citrus paradisi L.) and Orange (Citrus sinensis L.) Essential Oils. Food Control 2008, 19, 1130–1138. [Google Scholar] [CrossRef]
- Rajkowska, K.; Nowicka-Krawczyk, P.; Kunicka-Styczyńska, A. Effect of Clove and Thyme Essential Oils on Candida Biofilm Formation and the Oil Distribution in Yeast Cells. Molecules 2019, 24, 1954. [Google Scholar] [CrossRef] [PubMed]
- Bolton, M.D.; Riviera, V.; Secor, G.A. Identification of the G143A mutation associated with QoI resistance in Cercospora beticola field isolates from Michigan. Pest. Manag. Sci. 2013, 69, 35–39. [Google Scholar] [CrossRef]
- Ma, Z.; Michailides, T.J. Advances in understanding molecular mechanisms of fungicide resistance and molecular detection of resistant genotypes in phytopathogenic fungi. Crop Protection 2005, 24, 853–863. [Google Scholar] [CrossRef]
- Djeddi, S.; Bouchenah, N.; Settar, I.; Skaltsa, H.D. Composition and antimicrobial activity of the essential oil of Rosmarinus officinalis from Algeria. Chem. Nat. Comp. 2007, 43, 487–490. [Google Scholar] [CrossRef]
- Fagodia, S.K.; Singh, H.P.; Batish, D.R.; Kohli, R.K. Phytotoxicity and Cytotoxicity of Citrus Aurantiifolia Essential Oil and Its Major Constituents: Limonene and Citral. Ind. Crop. Prod. 2017, 108, 708–715. [Google Scholar] [CrossRef]
- Amini, M.; Safaie, N.; Salmani, M.J.; Shams-Bakhsh, M. Antifungal activity of three medicinal plant essential oils against some Phytopathogenic fungi. Trakia J. Sci. 2012, 10, 1–8. [Google Scholar]
- Kowalczyk, A.; Przychodna, M.; Sopata, S.; Bodalska, A.; Fecka, I. Thymol and Thyme Essential Oil—New Insights into Selected Therapeutic Applications. Molecules 2020, 25, 4125. [Google Scholar] [CrossRef]
- De Lira Mota, K.S.; de Oliveira Pereira, F.; de Oliveira, W.A.; Lima, I.O.; de Oliveira Lima, E. Antifungal Activity of Thymus vulgaris L. Essential Oil and its Constituent Phytochemicals against Rhizopus oryzae: Interaction with Ergosterol. Molecules 2012, 17, 14418–14433. [Google Scholar] [CrossRef]
- Al-Shahrani, M.H.; Mahfoud, M.; Anvarbatcha, R.; Athar, M.T.; Al Asmari, A. Evaluation of antifungal activity and cytotoxicity of Thymus vulgaris essential oil. Pharmacogn. Commun. 2017, 7, 34–40. [Google Scholar] [CrossRef]
- Gwiazdowski, R.; Gwiazdowska, D.; Marchwińska, K.; Juś, K.; Szutowska, J.; Bednarek-Bartsch, A.; Danielewicz, B. Właściwości fungistatyczne olejków eterycznych wobec wybranych patogenów rzepaku. Prog. Plant Prot. 2018, 58, 300–305. [Google Scholar] [CrossRef]
- Chen, G.W.; Lin, Y.H.; Lin, C.H.; Jen, H.C. Antibacterial Activity of Emulsified Pomelo (Citrus grandis Osbeck) Peel Oil and Water-Soluble Chitosan on Staphylococcus aureus and Escherichia coli. Molecules 2018, 23, 840. [Google Scholar] [CrossRef] [PubMed]
- Raspo, M.A.; Vignola, M.B.; Andreatta, A.E.; Juliani, H.R. Antioxidant and antimicrobial activities of citrus essential oils from Argentina and the United States. Food Biosci. 2020, 36, 100651. [Google Scholar] [CrossRef]
- Singh, P.; Shukla, R.; Prakash, B.; Kumar, A.; Singh, S.; Mishra, P.K.; Dubey, N.K. Chemical profile, antifungal, antiafla-toxigenic and antioxidant activity of Citrus maxima Burm. and Citrus sinensis (L.) Osbeck essential oils and their cyclic monoterpene, DL-limonene. Food Chem. Toxicol. 2010, 48, 1734–1740. [Google Scholar] [CrossRef]
- Kishore, G.K.; Pande, S.; Harish, S. Evaluation of essential oils and their components for broad-spectrum antifungal activity and control of late leaf spot and crown rot diseases in peanut. Plant Dis. 2007, 91, 375–379. [Google Scholar] [CrossRef]
- Santos-Gomes, P.C.; Fernandes-Ferreira, M. Organ- and Season-Dependent Variation in the Essential Oil Composition of Salvia officinalis L. Cultivated at Two Different Sites. J. Agric. Food Chem. 2001, 49, 2908–2916. [Google Scholar] [CrossRef]
- Chen, W.; Vermaak, I.; Viljoen, A. Camphor—A Fumigant during the Black Death and a Coveted Fragrant Wood in Ancient Egypt and Babylon—A Review. Molecules 2013, 18, 5434–5454. [Google Scholar] [CrossRef]
- Jaafar, M.; Mitri, S.; Nawas, T. Inhibition of Gram Negative Bacterial Growth and Biofilm Formation by Alpha Thujone. J. Pharm. Biol. Sci. 2018, 13, 40–47. [Google Scholar]
- Baykan Erel, S.; Reznicek, G.; Şenol, S.G.; Karabay Yavaşoğulu, N.Ü.; Konyalioğlu, S.; Zeybek, A.U. Antimicrobial and an-tioxidant properties of Artemisia L. species from western Anatolia. Turk. J. Biol. 2012, 36, 78–84. [Google Scholar] [CrossRef]
- Mighri, H.; Hajlaoui, H.; Akrout, A.; Najjaa, H.; Neffati, M. Antimicrobial and antioxidant activities of Artemisia herba-alba essential oil cultivated in Tunisian arid zone. C R. Cim. 2010, 13, 380–386. [Google Scholar] [CrossRef]
- Viljoen, A.; van Vuuren, S.; Ernst, E.; Klepser, M.; Demirci, B.; Başer, H.; van Wyk, B.E. Osmitopsis asteriscoides (Asteraceae)—The antimicrobial activity and essential oil composition of a Cape-Dutch remedy. J. Ethnopharmacol. 2003, 88, 137–143. [Google Scholar] [CrossRef] [PubMed]
- Amri, I.; Khammassi, M.; Gargouri, S.; Hanana, M.; Jamoussi, B.; Hamrouni, L.; Mabrouk, Y. Tunisian Pine Essential Oils: Chemical Composition, Herbicidal and Antifungal Properties. J. Essent. Oil Bear. Plants 2022, 25, 430–443. [Google Scholar] [CrossRef]
- Ustun, O.; Sezik, E.; Kurkcuoglu, M.; Baser, K.H.C. Study of the essential oil composition of Pinus sylvestris from Turkey. Chem. Nat. Compd. 2006, 42, 26–31. [Google Scholar] [CrossRef]
- Allenspach, M.; Valder, C.; Flamm, D.; Grisoni, F.; Steuer, C. Verification of Chromatographic Profile of Primary Essential Oil of Pinus sylvestris L. Combined with Chemometric Analysis. Molecules 2020, 25, 2973. [Google Scholar] [CrossRef]
- Medina-Romero, Y.M.; Rodriguez-Canales, M.; Rodriguez-Monroy, M.A.; Hernandez-Hernandez, A.B.; Delgado-Buenrostro, N.L.; Chirino, Y.I.; Cruz-Sanchez, T.; Garcia-Tovar, C.G.; Canales-Martinez, M.M. Effect of the Essential Oils of Bursera morelensis and Lippia graveolens and Five Pure Compounds on the Mycelium, Spore Production, and Germination of Species of Fusarium. J. Fungi 2022, 8, 617. [Google Scholar] [CrossRef]
- Spychalski, M.; Kukawka, R.; Krzesiński, W.; Spiżewski, T.; Michalecka, M.; Poniatowska, A.; Puławska, J.; Mieszczakowska-Frąc, M.; Panasiewicz, K.; Kocira, A.; et al. Use of New BTH Derivative as Supplement or Substitute of Standard Fungicidal Program in Strawberry Cultivation. Agronomy 2021, 11, 1031. [Google Scholar] [CrossRef]
- Kukawka, R.; Spychalski, M.; Smiglak, M.; Gaj, R. The Biostimulation Activity of Two Novel Benzothiadiazole Derivatives in the Tomato Cultivation. Sustainability 2024, 16, 5191. [Google Scholar] [CrossRef]
- Czerwoniec, P.; Kukawka, R.; Spychalski, M.; Koczura, R.; Mokracka, J.; Smiglak, M. New Biologically Active Ionic Liquids with Benzethonium Cation-Efficient SAR Inducers and Antimicrobial Agents. Pest. Manag. Sci. 2024, 80, 3047–3055. [Google Scholar] [CrossRef]
- Kukawka, R.; Spychalski, M.; Grzempa, B.; Smiglak, M.; Górski, D.; Gaj, R.; Kiniec, A. The Use of a New Ionic Derivative of Salicylic Acid in Sugar Beet Cultivation. Agronomy 2024, 14, 827. [Google Scholar] [CrossRef]
- Spychalski, M.; Kukawka, R.; Prasad, R.; Borodynko-Filas, N.; Stępniewska-Jarosz, S.; Turczański, K.; Smiglak, M. A New Benzothiadiazole Derivative with Systemic Acquired Resistance Activity in the Protection of Zucchini (Cucurbita pepo convar. giromontiina) against Viral and Fungal Pathogens. Plants 2023, 12, 43. [Google Scholar] [CrossRef]
- Hanse, B.; Schneider, J.H.M.; Termorshuizen, A.J.; Varrelmann, M. Pests and Diseases Contribute to Sugar Beet Yield Difference between Top and Averagely Managed Farms. Crop Prot. 2011, 30, 671–678. [Google Scholar] [CrossRef]
- Nabrdalik, M.B.; Moliszewska, E.B. Tubercle Disease of Sugar Beets, the Lost Pathogen, and the Thin Border between Pathogenicity and Stimulatory Effect. J. Plant Prot. Res. 2023, 63, 459–467. [Google Scholar]
- Raveau, R.; Fontaine, J.; Lounès-Hadj Sahraoui, A. Essential Oils as Potential Alternative Biocontrol Products against Plant Pathogens and Weeds: A Review. Foods 2020, 9, 365. [Google Scholar] [CrossRef] [PubMed]
- Thiviya, P.; Gunawardena, N.; Gamage, A.; Madhujith, T.; Merah, O. Apiaceae Family as a Valuable Source of Biocidal Components and their Potential Uses in Agriculture. Horticulturae 2022, 8, 614. [Google Scholar] [CrossRef]
- Serralutzu, F.; Stangoni, A.; Amadou, B.; Tijan, D.; Re, G.A.; Marceddu, S.; Dore, A.; Bullitta, S. Essential Oil Composition and Yield of a Rosmarinus officinalis L. Natural Population with an Extended Flowering Season in a Coastal Mediterranean Environment and Perspectives for Exploitations. Genet. Resour. Crop Evol. 2020, 67, 1777–1793. [Google Scholar] [CrossRef]
- Md Othman, S.N.A.; Hassan, M.A.; Nahar, L.; Basar, N.; Jamil, S.; Sarker, S.D. Essential Oils from the Malaysian Citrus (Rutaceae) Medicinal Plants. Medicines 2016, 3, 13. [Google Scholar] [CrossRef]
- Tsai, M.-L.; Lin, C.-D.; Khoo, K.A.; Wang, M.-Y.; Kuan, T.-K.; Lin, W.-C.; Zhang, Y.-N.; Wang, Y.-Y. Composition and Bioactivity of Essential Oil from Citrus grandis (L.) Osbeck ‘Mato Peiyu’ Leaf. Molecules 2017, 22, 2154. [Google Scholar] [CrossRef]
- Hosni, K.; Hassen, I.; Chaâbane, H.; Jemli, M.; Dallali, S.; Sebei, H.; Casabianca, H. Enzyme-Assisted Extraction of Essential Oils from Thyme (Thymus capitatus L.) and Rosemary (Rosmarinus officinalis L.): Impact on Yield, Chemical Composition and Antimicrobial Activity. Ind. Crops Prod. 2013, 47, 291–299. [Google Scholar] [CrossRef]

| Fungicide | Active Ingredients |
|---|---|
| Safir 125 SC | 125 g/L epoxiconazole |
| Horizon 250 EW | 250 g/L tebuconazole |
| Dafne 250 EC | 250 g/L difenoconazole |
| Amistar 250 SC | 250 g/L azoxystrobin |
| Andros 750 EC | 750 g/L fenpropidin |
| Year of Experiment | Name and Symbol of Location | Geographical Coordinates | Soil Characteristics | pH |
|---|---|---|---|---|
| 2022 | Falęcin | 53°13′06″ N 18°36′33″ E | sandy loam | 6.7 |
| 2023 | Falęcin | 53°13′06″ N 18°36′33″ E | sandy loam | 6.6 |
| Variant of Treatment | The Numbering and Dates of Treatments | ||||
|---|---|---|---|---|---|
| 4 July 2022 | 12 July 2022 | 18 July 2022 | 27 July 2022 | 17 August 2022 | |
| I | II | III | IV | V | |
| UTC | |||||
| SFP | Makler 250 SEEminent 125 ME | Spyrale 475 EC | |||
| Thyme EO 0.05% | Thyme EO 0.05% | Thyme EO 0.05% | Thyme EO 0.05% | Thyme EO 0.05% | |
| Thyme EO 0.1% | Thyme EO 0.1% | Thyme EO 0.1% | Thyme EO 0.1% | Thyme EO 0.1% | |
| Variant of Treatment | The Number and Dates of Treatments | ||||
|---|---|---|---|---|---|
| 7 July 2023 | 14 July 2023 | 20 July 2023 | 28 July 2023 | 21 August 2023 | |
| I | II | III | IV | V | |
| UTC | |||||
| SFP | Makler 250 SEEminent 125 ME | Spyrale 475 EC | |||
| Thyme EO 0.05% | Thyme EO 0.05% | Thyme EO 0.05% | Thyme EO 0.05% | Thyme EO 0.05% | |
| Thyme EO 0.1% | Thyme EO 0.1% | Thyme EO 0.1% | Thyme EO 0.1% | Thyme EO 0.1% | |
| No. Isolate | Epoxiconazole | Tebuconazole | Difenoconazole | Azoxystrobin | Fenpropidin | The Number of Substances the Isolate Is Resistant To |
|---|---|---|---|---|---|---|
| 4 | + | + | + | + | + | 5 |
| 35 | + | + | + | + | + | 5 |
| 102 | + | + | + | + | − | 4 |
| 112 | + | + | + | + | − | 4 |
| 141 | + | + | + | − | + | 4 |
| 58 | + | + | − | + | + | 4 |
| 68 | + | + | − | + | + | 4 |
| 73 | + | + | − | + | − | 3 |
| 77 | + | + | − | + | − | 3 |
| 88 | − | − | − | + | + | 2 |
| 159 | − | − | − | + | + | 2 |
| 2 | − | − | + | + | − | 2 |
| 124 | − | − | + | + | − | 2 |
| 30 | − | + | − | + | − | 2 |
| 80 | − | + | − | + | − | 2 |
| 11 | + | + | − | − | − | 2 |
| 45 | − | − | − | + | − | 1 |
| 130 | − | − | − | + | − | 1 |
| 15 | − | − | − | − | + | 1 |
| 10 | − | − | − | − | − | 0 |
| 33 | − | − | − | − | − | 0 |
| Component | RI * | Area (%) | ||||
|---|---|---|---|---|---|---|
| Grapefruit | Rosemary | Pine | Sage | Thyme | ||
| α-pinene | 937 | 2.6 | 18.4 | 21.9 | 4.6 | |
| camphene | 955 | 5.4 | 3.8 | 6.4 | ||
| β-pinene | 982 | 9.8 | 5.9 | |||
| δ-3-carene | 1012 | 3.1 | 9.8 | |||
| ρ-cymene | 1028 | 3.1 | 4.5 | 16.0 | ||
| β-phellandrene | 1030 | 1.8 | ||||
| limonene | 1033 | 83.5 | 1.2 | 2.6 | 1.4 | |
| 1,8-cineole | 1037 | 17.4 | 11.8 | |||
| α-thujone (cis) | 1099 | 25.5 | ||||
| linalool | 1100 | 3.8 | 2.2 | |||
| β-thujone (trans) | 1110 | 5.4 | ||||
| isoborneol | 1153 | 1.9 | ||||
| camphor | 1155 | 19.7 | 20.7 | |||
| borneol | 1177 | 2.9 | 3.5 | |||
| menthol | 1182 | 5.1 | ||||
| α-terpineol | 1188 | 4.5 | 8.0 | 3.2 | ||
| γ-terpineol | 1196 | 7.3 | ||||
| bornyl acetate | 1288 | 7.9 | ||||
| thymol | 1293 | 57.0 | ||||
| carvacrol | 1302 | 2.3 | ||||
| β-caryophyllene | 1415 | 3.3 | ||||
| α-caryophyllene | 1489 | 4.7 | ||||
| caryophyllene oxide | 1583 | 12.5 |
| Isolate | Grapefruit EO | Rosemary EO | Pine EO | Sage EO | Thyme EO |
|---|---|---|---|---|---|
| MIC Value [mL/L] | |||||
| 4 | 10.0 | 5.0 | 10.0 | 10.0 | 0.313 |
| 35 | >10.0 | >10.0 | 10.0 | >10.0 | 0.313 |
| 102 | >10.0 | 5.0 | 2.5 | 10.0 | 0.313 |
| 112 | >10.0 | 5.0 | 10.0 | >10.0 | 0.313 |
| 141 | >10.0 | 5.0 | 5.0 | >10.0 | 0.313 |
| 58 | >10.0 | >10.0 | 10.0 | >10.0 | 0.625 |
| 68 | >10.0 | >10.0 | >10.0 | >10.0 | 0.313 |
| 73 | >10.0 | 5.0 | 10.0 | >10.0 | 0.313 |
| 77 | >10.0 | 5.0 | 10.0 | 10.0 | 1.25 |
| 88 | >10.0 | >10.0 | >10.0 | >10.0 | 0.313 |
| 159 | >10.0 | >10.0 | 10.0 | >10.0 | 0.313 |
| 2 | >10.0 | >10.0 | 5.0 | >10.0 | 0.313 |
| 124 | >10.0 | 5.0 | 10.0 | 10.0 | 0.625 |
| 30 | >10.0 | >10.0 | 10.0 | >10.0 | 0.625 |
| 80 | >10.0 | >10.0 | 10.0 | 10.0 | 0.313 |
| 11 | >10.0 | >10.0 | 10.0 | >10.0 | 0.313 |
| 45 | >10.0 | 10.0 | 10.0 | >10.0 | 0.625 |
| 130 | >10.0 | 10.0 | 10.0 | >10.0 | 0.313 |
| 15 | >10.0 | 5.0 | 10.0 | 10.0 | 0.625 |
| 10 | >10.0 | >10.0 | 10.0 | >10.0 | 0.313 |
| 33 | >10.0 | >10.0 | 10.0 | >10.0 | 0.313 |
| Variant of Treatment | Root Yield [t ha−1] | Sugar Polarization [%] | Potassium Content [mmol 1000 g−1 of Pulp] | Sodium Content [mmol 1000 g−1 of Pulp] | α-Amino Nitrogen Content [mmol 1000 g−1 of pulp] | Technological Sugar Yield [t ha−1] | Infected Leaf Area [%] |
|---|---|---|---|---|---|---|---|
| UTC | 56.46 a | 16.03 a | 36.30 a | 9.48 a | 17.05 a | 7.90 a | 100 c |
| SFP | 66.62 c | 16.88 a | 37.75 a | 7.78 a | 20.45 a | 9.83 c | 70 a |
| Thyme EO 0.05% | 59.26 ab | 16.29 a | 35.43 a | 9.83 a | 20.53 a | 8.40 ab | 85 b |
| Thyme EO 0.1% | 61.85 b | 16.35 a | 35.83 a | 11.05 a | 22.00 a | 8.77 b | 80 ab |
| Variant of Treatment | Root Yield [t ha−1] | Sugar Polarization [%] | Potassium Content [mmol 1000 g−1 of Pulp] | Sodium Content [mmol 1000 g−1 of Pulp] | α-Amino Nitrogen Content [mmol 1000 g−1 of Pulp] | Technological Sugar Yield [t ha−1] | Infected Leaf Area [%] |
|---|---|---|---|---|---|---|---|
| UTC | 56.00 a | 17.10 a | 39.25 a | 5.35 a | 17.73 a | 8.44 a | 100 c |
| SFP | 69.71 c | 17.58 a | 39.53 a | 5.55 a | 19.00 a | 10.81 c | 57.5 a |
| Thyme EO 0.05% | 60.14 ab | 17.19 a | 38.80 a | 4.48 a | 18.88 a | 9.10 ab | 72.5 b |
| Thyme EO 0.1% | 64.34 b | 17.10 a | 40.20 a | 6.00 a | 18.78 a | 9.67 b | 70 b |
Disclaimer/Publisher’s Note: The statements, opinions and data contained in all publications are solely those of the individual author(s) and contributor(s) and not of MDPI and/or the editor(s). MDPI and/or the editor(s) disclaim responsibility for any injury to people or property resulting from any ideas, methods, instructions or products referred to in the content. |
© 2024 by the authors. Licensee MDPI, Basel, Switzerland. This article is an open access article distributed under the terms and conditions of the Creative Commons Attribution (CC BY) license (https://creativecommons.org/licenses/by/4.0/).
Share and Cite
Kiniec, A.; Spychalski, M.; Miziniak, W.; Palacz, M.; Kukawka, R. The Use of Thyme (Thymus vulgaris) Essential Oil for Controlling Cercospora Leaf Spot (Cercospora beticola) on Sugar Beets (Beta vulgaris). Agriculture 2024, 14, 2017. https://doi.org/10.3390/agriculture14112017
Kiniec A, Spychalski M, Miziniak W, Palacz M, Kukawka R. The Use of Thyme (Thymus vulgaris) Essential Oil for Controlling Cercospora Leaf Spot (Cercospora beticola) on Sugar Beets (Beta vulgaris). Agriculture. 2024; 14(11):2017. https://doi.org/10.3390/agriculture14112017
Chicago/Turabian StyleKiniec, Agnieszka, Maciej Spychalski, Wojciech Miziniak, Magdalena Palacz, and Rafal Kukawka. 2024. "The Use of Thyme (Thymus vulgaris) Essential Oil for Controlling Cercospora Leaf Spot (Cercospora beticola) on Sugar Beets (Beta vulgaris)" Agriculture 14, no. 11: 2017. https://doi.org/10.3390/agriculture14112017
APA StyleKiniec, A., Spychalski, M., Miziniak, W., Palacz, M., & Kukawka, R. (2024). The Use of Thyme (Thymus vulgaris) Essential Oil for Controlling Cercospora Leaf Spot (Cercospora beticola) on Sugar Beets (Beta vulgaris). Agriculture, 14(11), 2017. https://doi.org/10.3390/agriculture14112017

